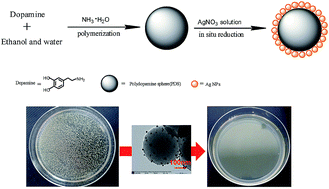
Graphical abstract: Facile synthesis of novel size-controlled antibacterial hybrid spheres using silver nanoparticles loaded with poly-dopamine spheres

Facile synthesis of novel size-controlled antibacterial hybrid spheres using silver nanoparticles loaded with poly-dopamine spheres†
Abstract
Silver nanoparticles have been proven to exhibit excellent antimicrobial activity, but problems such as aggregation and toxicity limit their practical application. To solve these problems, a kind of sub-micrometer poly-dopamine spheres loaded with silver nanoparticles (Ag@PDS) were fabricated using a facile method. Silver nitrate was reduced by poly-dopamine spheres (PDS) without surface modification, and no other reducing agent added. This entire preparation process is very green, simple and efficient. As a result, Ag NPs have been fixed and uniformly dispersed onto the surface of the PDS, which can effectively prevent Ag NPs from aggregating or oxidizing during their application. Because the size of the uniform hybrid sphere is easily controlled by adjusting the ratio of ammonia to dopamine, it is convenient to fabricate hybrid spheres with desired sizes. These hybrids are capable of completely inhibiting bacterial growth because of their excellent antibacterial properties. Finally, the prospect of the organismal level impact of the Ag@PDS hybrid has also been proposed.

- This article is part of the themed collection: Biomaterials
Please wait while we load your content...
Please wait while we load your content...